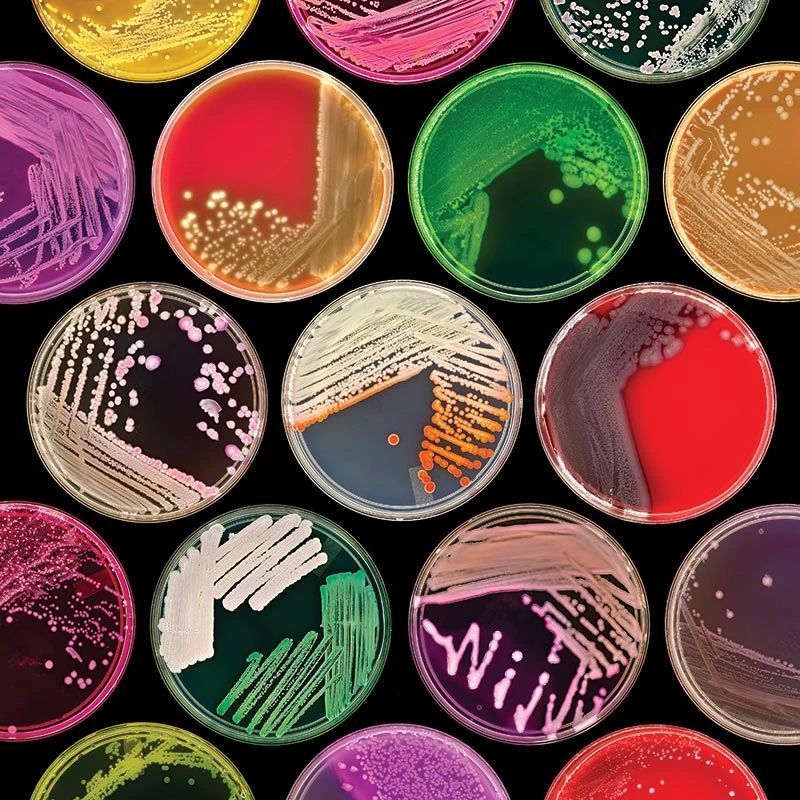

從零開始教你養(yǎng)細菌,一文掌握細菌培養(yǎng)核心要點
2025-06-20 10:06:57
來源/作者:普拉特澤-生物醫(yī)學整體課題外包平臺
Question:細菌該如何培養(yǎng)?(普拉特澤生物提供長期穩(wěn)定的細胞實驗外包服務)
答:
細菌培養(yǎng)被廣泛應用于生物化學與分子生物學的實驗,例如基因克隆與表達、DNA與RNA的提取、酶的生產(chǎn)、細菌與細胞共培養(yǎng)等。下面以基因克隆表達中大腸桿菌(生長周期短)的培養(yǎng)、鳥分枝桿菌(生長周期長)的培養(yǎng)為例分享主要的實驗步驟和注意事項:
圖片來源:https://www.atcc.org/resources/culture-guides/bacteriology-culture-guide
2 實驗步驟
2.1 準備工作
(1)培養(yǎng)基準備:LB培養(yǎng)基(大腸桿菌)、Middle brook培養(yǎng)基(鳥分枝桿菌)
(2)試劑準備:蛋白胨、酵母提取物、氯化鈉、瓊脂、購買Middle brook 7H10固體培養(yǎng)基和Middle Brook 7H9肉湯培養(yǎng)基、蒸餾水、抗生素(氨芐青霉素、羧芐青霉素、兩性霉素B)、購買增菌液。
(3)儀器、耗材準備:細菌培養(yǎng)皿、50mL無菌離心管、試管、錐形瓶、接種環(huán)、酒精燈、打火機、高壓蒸汽滅菌鍋、37℃恒溫培養(yǎng)箱、生物安全柜、超凈工作臺、恒溫搖床。
2.2 實驗步驟
(1)滅菌:按照下面成分(見表1)配置培養(yǎng)基,使用高壓蒸汽滅菌法121℃、30min進行滅菌處理。接著將準備的細菌培養(yǎng)皿、50mL無菌離心管、錐形瓶、接種環(huán)、酒精燈等物品放置在超凈工作臺打開紫外線照射至少30min。
(2)培養(yǎng)基配置比例:培養(yǎng)基的配置需要按照質(zhì)量比例要求例如LB培養(yǎng)基需按照質(zhì)量(g)比(2:1:2)分別稱取蛋白胨、酵母提取物、氯化鈉,購買的分枝桿菌培養(yǎng)基按照說明書根據(jù)使用的量進行配置。固體培養(yǎng)基的配置加入瓊脂粉一般按照15.0 g/L的比例加入。

(3)倒平板:根據(jù)細菌的生長狀況設置平板的厚度,培養(yǎng)基的量通常的大腸桿菌10mL/平板(培養(yǎng)基層厚度約3-4mm),而分枝桿菌需要20mL/平板(培養(yǎng)基層厚度約5-6mm)。
(4)活化、接種:菌種的來源可以是涂布的平板也可以是保存在-80℃的菌種。關閉紫外線,打開超凈工作臺通風,點燃酒精燈,將接種環(huán)放置在酒精燈上灼燒至紅色,放置在火焰周圍冷卻。挑取適量菌落或者菌液進行劃線,使得菌液以多至少的量(圖1)分布在培養(yǎng)基表面。

(5)培養(yǎng):可將處理好的培養(yǎng)基用封口膜封閉好,正置37℃恒溫培養(yǎng)箱30min左右,然后倒置培養(yǎng)。
(6)觀察:按照細菌的生長周期觀察期生長狀況,大腸桿菌一般需要12~16h,而分枝桿菌生長緩慢需要1~4周左右。
(7)液體培養(yǎng):一般在活化、接種后,劃線的平板長出清晰的單克隆菌落,此時我們可以挑取單菌落進行擴大培養(yǎng)。將液體培養(yǎng)基按15~20mL的量倒入無菌離心管或者10mL左右倒入試管,在灼燒接種環(huán)滅菌冷卻后將菌落挑取伸入試管輕輕晃動,使菌落落入液體培養(yǎng)基,封口膜封閉試管或者離心管;最后放置恒溫搖床進行培養(yǎng)。
3 注意事項
(1)細菌培養(yǎng)要求所涉及的物品、操作均要求無菌,否則會存在其他雜菌的污染。
(2)滅菌之前注意按照菌的生長情況調(diào)節(jié)培養(yǎng)基的pH值例如LB培養(yǎng)基要求PH值在7.0~7.4之間,防止偏酸或者偏堿的環(huán)境影響菌的生長。
(3)培養(yǎng)基配置時,使用蒸餾水充分溶解;滅菌完成后,固體培養(yǎng)基可以暫放烘干箱后倒平板。
(4)抗生素、增菌液一定是等待培養(yǎng)基稍稍冷卻至手可以正常觸碰錐形時加入,否則抗生素會失效。
(5)所使用的物品基本上放置在酒精燈的周圍,例如倒平板時,灼燒瓶口后一手操作平板一手操作錐形瓶倒平板(圖2)。

(6)為了防止平板產(chǎn)生水汽,可以將平板半敞開在酒精燈周圍,也可以全部疊放在酒精燈的旁邊(圖3)

(7)分枝桿菌生長周期長,需要按照說明書的比例加入增菌液、抗生素以及倒厚平板,保證長時間的培養(yǎng)有足夠營養(yǎng)成分和良好的生長環(huán)境。
(8)鳥分枝桿菌屬于非結(jié)核分枝桿菌,存在一定的感染性,使用前需要用60℃水浴滅活30min,同時在生物安全柜中進行操作,防止感染。
(9)在實驗操作過程中,需佩戴好手套、口罩、穿好實驗服等。
(10)平板處理,有一定感染性的平板需要集中滅菌處理后再丟棄。
(11)注意標記平板,一般標記好時間、菌種名稱、培養(yǎng)條件等。
注:文源公眾號實驗老司機
冰凍三尺,非一日之寒,普拉特澤致力于幫助廣大科研工作者解細胞培養(yǎng)中的各方面問題,不但授人以魚,亦授人以漁。
